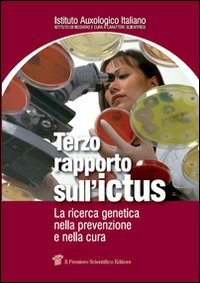
Terzo rapporto sull'ictus. La ricerca genetica nella prevenzione e nella cura

Editore
Il Pensiero Scientifico
902 libri per questo editore.

Non disponibile
Medicina e professioni
Dietetica e nutrizione. Clinica, terapia e organizzazione
85,00 €

Non disponibile
Società e antropologia
La relazione adolescenti-adulti. Riflessioni psicoanalitiche ed esperienze cliniche
18,50 €

Non disponibile
Medicina e professioni
Passaggi. Storia ed evoluzione del concetto di morte cerebrale
30,00 €


Non disponibile
Crescita personale
Ritardare l'invecchiamento è possibile. Come la medicina spaziale ci insegna a riconquistare la salute e il benessere
18,00 €
Non disponibile
Medicina e professioni
Obesità e genetica: oltre lo stile di vita. 7° Rapporto sull'obesità in Italia
35,00 €
Non disponibile
Medicina e professioni
Il carcinoma renale. Basi per un moderno approccio multidisciplinare
24,50 €
Non disponibile
Medicina e professioni
Terzo rapporto sull'ictus. La ricerca genetica nella prevenzione e nella cura
36,00 €

Non disponibile
Crescita personale
100 farmaci per il pronto soccorso. Prove di efficacia in emergenza
19,00 €

Non disponibile
Medicina e professioni
Accreditamento e qualità: i servizi farmaceutici ospedalieri e territoriali delle aziende sanitarie
15,00 €

Non disponibile
Medicina e professioni
Accreditamento e servizi di salute mentale. Appunti per una discussione
15,00 €


